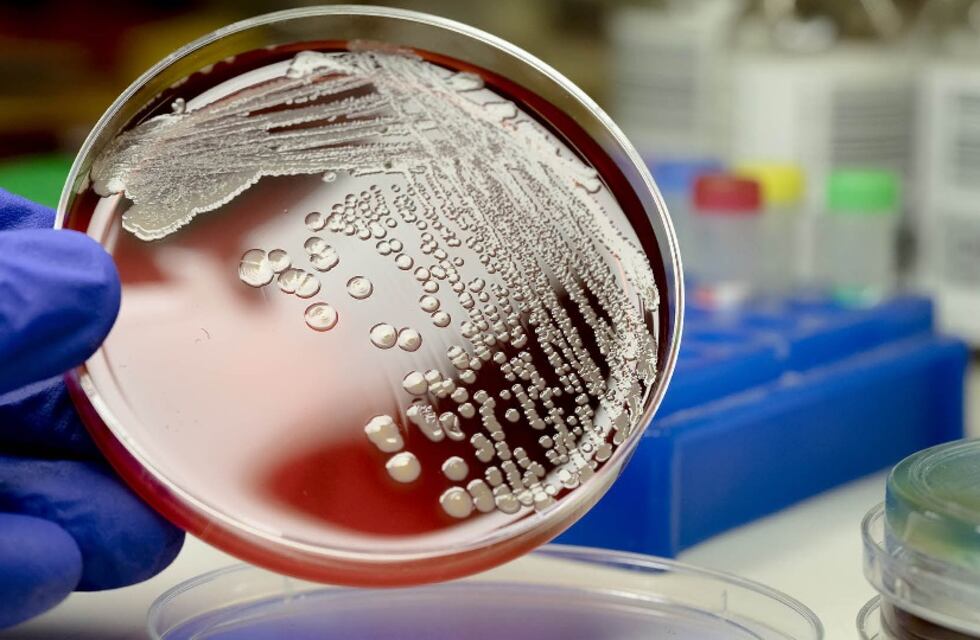
Alerta en San Juan: detectaron casos de una enfermedad viral y de alto riesgo

Desde el Ministerio de Salud Pública de San Juan informaron de la detección de tres casos de meningitis viral, confirmados por la División de Epidemiología.

No hay vínculo epidemiológico
En el informe de Salud, confirmaron que no hay vínculo epidemiológico entre los casos detectados y corresponden a hombres mayores de edad.
- Primer paciente: sexo masculino de 19 años, con diversas patologías, oriundo de Chimbas
- Segundo paciente: 36 años de sexo masculino, oriundo de Chimbas
- Tercer paciente: 45 años, masculino oriundo de Santa Lucia
Los tres pacientes se encuentran internados en el Hospital Guillermo Rawson con pronóstico reservado.
¿Qué es la Meningitis?
La meningitis es la inflamación del tejido delgado que rodea el cerebro y la médula espinal, llamada meninge. Existen varios tipos de meningitis aunque la más común es:
- Meningitis viral: que ocurre cuando un virus penetra en su organismo a través de la nariz o la boca y se traslada al cerebro.
¿Cómo saber si una persona tiene meningitis?
Por medio de las radiografías o tomografías computarizadas de tórax o de los senos paranasales también pueden mostrar si hay una infección asociada con la meningitis.
Punción lumbar: para tener un diagnóstico definitivo de meningitis, necesitarás una punción lumbar para recolectar líquido cefalorraquídeo.
¿Cuáles son los síntomas?
Según se desarrolla la meningitis, aparecen los signos meníngeos clásicos, fundamentalmente expresados por una rigidez en la nuca con intenso dolor a su movilización, y los vómitos ‘en escopetazo’, es decir, proyectivos y sin náusea.
Todo lo que tenés que saber sobre la meningitis